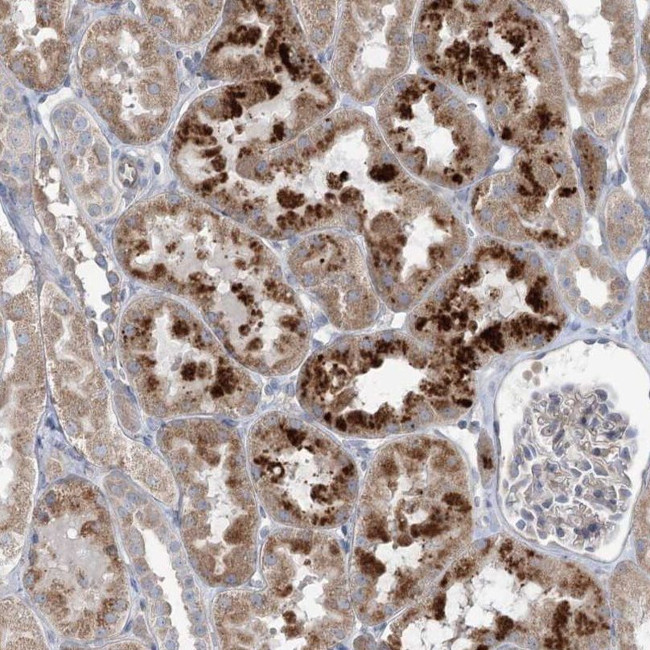
SCN11A Antibody in Immunohistochemistry (IHC)

Search
Invitrogen
SCN11A Polyclonal Antibody
{{$productOrderCtrl.translations['antibody.pdp.commerceCard.promotion.promotions']}}
{{$productOrderCtrl.translations['antibody.pdp.commerceCard.promotion.viewpromo']}}
{{$productOrderCtrl.translations['antibody.pdp.commerceCard.promotion.promocode']}}: {{promo.promoCode}} {{promo.promoTitle}} {{promo.promoDescription}}. {{$productOrderCtrl.translations['antibody.pdp.commerceCard.promotion.learnmore']}}
产品信息
PA5-57795
种属反应
宿主/亚型
分类
类型
抗原
偶联物
形式
浓度
规格
纯化类型
保存液
内含物
保存条件
运输条件
RRID
产品详细信息
Immunogen sequence: PLKKLYEPIV TTTKRKEEER GAAIIQKAFR KYMMKVTKGD QGDQNDLENG PHSPLQTLCN GDLSSFGVAK GKVHCD
Highest antigen sequence identity to the following orthologs: Mouse - 59%, Rat - 61%.
靶标信息
Epithelial sodium channels are amiloride-sensitive members of the Degenerin/epithelial sodium channel (Deg/ENaC) superfamily of ion channels. Members of this superfamily of ion channels share organizational similarity in that they all possess two short intracellular amino and carboxyl termini, two short membrane spanning segments, and a large extracellular loop with a conserved cysteine-rich region. There are three homologous isoforms of the ENaC (alpha, beta, and gamma) protein. ENaC in the kidney, lung, and colon plays an essential role in trans-epithelial sodium and fluid balance. ENaC also mediates aldosterone-dependent sodium reabsorption in the distal nephron of the kidney, thus regulating blood pressure. ENaC is thought to be regulated, in part, through association with the cystic fibrosis transmembrane conductance regulator (CFTR) chloride ion channel. Gain-of-function mutations in beta- or gamma-ENaC can cause severe arterial hypertension (Liddels syndrome) and loss-of-function mutations in alpha- or beta-ENaC causes pseudohypoaldosteronism (PHA-1).
仅用于科研。不用于诊断过程。未经明确授权不得转售。
篇参考文献 (0)
生物信息学
蛋白别名: hNaN; NaN alpha subunit; Peripheral nerve sodium channel 5; PN5; Sensory neuron sodium channel 2; Sodium channel protein type 11 subunit alpha; Sodium channel protein type XI subunit alpha; sodium channel, voltage-gated, type XI, alpha; sodium channel, voltage-gated, type XI, alpha polypeptide; sodium channel, voltage-gated, type XI, alpha subunit; sodium channel, voltage-gated, type XII, alpha polypeptide; Voltage-gated sodium channel subunit alpha Nav1.9
基因别名: FEPS3; HSAN7; NaN; NAV1.9; PN5; SCN11A; SCN12A; SNS-2; SNS2
UniProt ID: (Human) Q9UI33
Entrez Gene ID: (Human) 11280